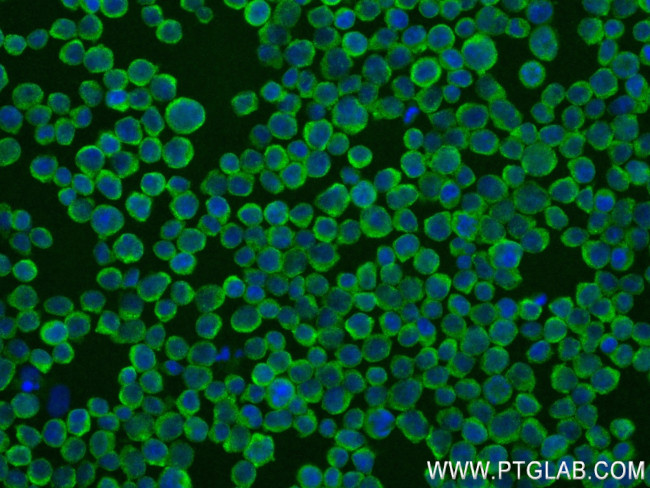
CYFIP2 Antibody in Immunocytochemistry (ICC/IF)
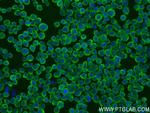
CYFIP2 Antibody in Immunocytochemistry (ICC/IF)

Search
Proteintech
CYFIP2 Recombinant Rabbit Monoclonal Antibody (240909E3)
{{$productOrderCtrl.translations['antibody.pdp.commerceCard.promotion.promotions']}}
{{$productOrderCtrl.translations['antibody.pdp.commerceCard.promotion.viewpromo']}}
{{$productOrderCtrl.translations['antibody.pdp.commerceCard.promotion.promocode']}}: {{promo.promoCode}} {{promo.promoTitle}} {{promo.promoDescription}}. {{$productOrderCtrl.translations['antibody.pdp.commerceCard.promotion.learnmore']}}
产品信息
83845-3-RR
种属反应
宿主/亚型
Expression System
分类
类型
克隆号
抗原
偶联物
形式
浓度
纯化类型
保存液
内含物
保存条件
运输条件
产品详细信息
Immunogen sequence: CYNGSTNRF VRTAIPFTQE PQRDKPANVQ PYYLYGSKPL NIAYSHIYSS YRNFVGPPHF KTICRLLGYQ GIAVVMEELL KIVKSLLQGT ILQYVKTLIE VMPKICRLPR HEYGSPGILE FFHHQLKDII EYAELKTDVF QSLREVGNAI LFCLLIEQAL SQEEVCDLLH AAPFQNILPR VYIKEGERLE VRMKRLEAKY APLHLVPLIE RLGTPQQIAI AREGDLLTKE RLCCGLSMFE VILTRIRSYL QDPIWRGPPP TNGVMHVDEC VEFHRLWSAM QFVYCIPVGT NEFTAEQCFG DGLNWAGCSI IVLLGQQRRF DLFDFCYHLL KVQRQDGKDE IIKNVPLKKM ADRIRKYQIL NNEVFAILNK YMKSVETDSS TVEHVRCFQP PIHQSLATTC
靶标信息
CYFIP2 (Cytoplasmic FMR1-interacting protein 2, p53-inducible protein 121) is a 1,278 amino acid protein encoded by the human gene CYFIP2. CYFIP2 belongs to the CYFIP family and is involved in T-cell adhesion and p53-dependent induction of apoptosis. It interacts with FMR1, FXR1 and FXR2 and is a component of the WAVE1 complex composed of Abi-2, CYFIP2, C3orf10/HSPC300, NAP125 and WASF1/WAVE1. Upon binding to activated Rac 1, CYFIP2 causes the complex to dissociate, releasing activated WASF1. The CYFIP2 promoter contains a p53-responsive element that confers p53 binding as well as transcriptional activation of a heterologous reporter. Induced expression of CYFIP2 is sufficient for caspase activation and cellular apoptosis, reminiscent of p53 activation.
仅用于科研。不用于诊断过程。未经明确授权不得转售。
篇参考文献 (0)
生物信息学
蛋白别名: CYFIP2; Cytoplasmic FMR1-interacting protein 2; p53-inducible protein 121
基因别名: CYFIP2; KIAA1168; PIR121
UniProt ID: (Human) Q96F07
Entrez Gene ID: (Human) 26999